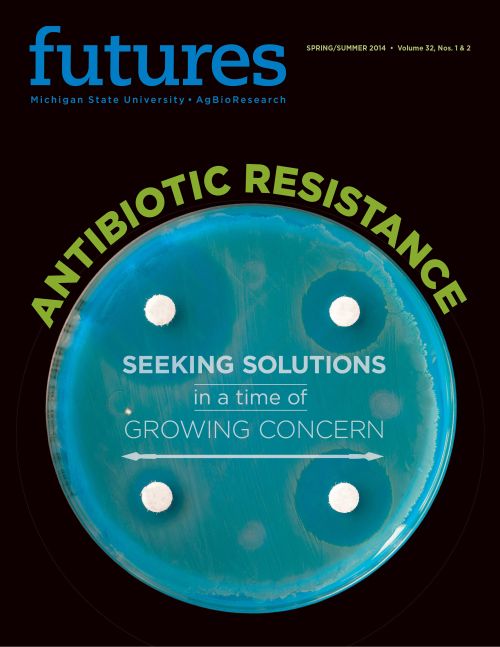

Antibiotic resistance: Tackling a tough, undeniably important topic
In this issue of Futures, we explore some of the research taking place at Michigan State University to help combat antibiotic resistance.
I recall standing at the kitchen counter trying to muster the courage to drink the dose of smelly syrup staring me in the eye. My mother intently watching over me,“Just plug your nose and drink it. It will make you better.” As usual, she was right. After a couple days of choking down the medicine, my health usually improved. Fast forward 30 years and I was the mom making the same plea to my young sons with a bit of added commentary: “At least yours is bubble gum-flavored.”
For generations, society has become reliant on antibiotics to cure a number of illnesses and diseases, some even life-threatening. Today, however, there is concern that we could be moving toward a “post-antibiotic era,” a time when our current supply of antibiotics is no longer useful. Unquestionably the thought of becoming ill with an infection that is not treatable by modern medicine is daunting. This is likely preventable, however, as long as society is more judicious about the use of these drugs and pharmaceutical companies bring new antibiotics to the marketplace.
In this issue of Futures, we explore some of the research taking place at Michigan State University to help combat this serious problem. To be clear, our intent is not to place blame or point fingers. Enough of that has already taken place. Instead we have interviewed some of our leading researchers examining the issue from various perspectives — human medicine, animal health and environmental impacts. At the same time, we realize this is a very complex topic and that we have only begun to scratch the surface.
At the very minimum, we hope that the articles in this magazine serve as a dialogue starter because finding solutions to attain optimal health for humans, animals and the environment has never been more important. By now, nearly everyone has heard of antimicrobial resistance, or drug resistance. Labeled by the Centers for Center for Disease Control and Prevention as one of the most urgent health threats facing society today, it is a topic of news stories around the globe. There has been progress, but there is still a long way to go.My personal outlook on antibiotic use has certainly changed in recent years. I’ll stick out a running nose and congestion longer than I would have before and all the while, my mother insisting a doctor’s prescription is the only remedy. Overcoming the generational beliefs and sometimes misbeliefs (e.g. antibiotics will get rid of a cold — NOT SO!) is perhaps the toughest feat of all.
But let’s face it, that nasty-tasting medicine (no wonder it kills bacteria!) - when properly prescribed — does pack a powerful punch against many serious illnesses and diseases. I sure hope it continues to be around to save lives and, less importantly, of course, to serve as a childhood rite of passage.



 Print
Print Email
Email





